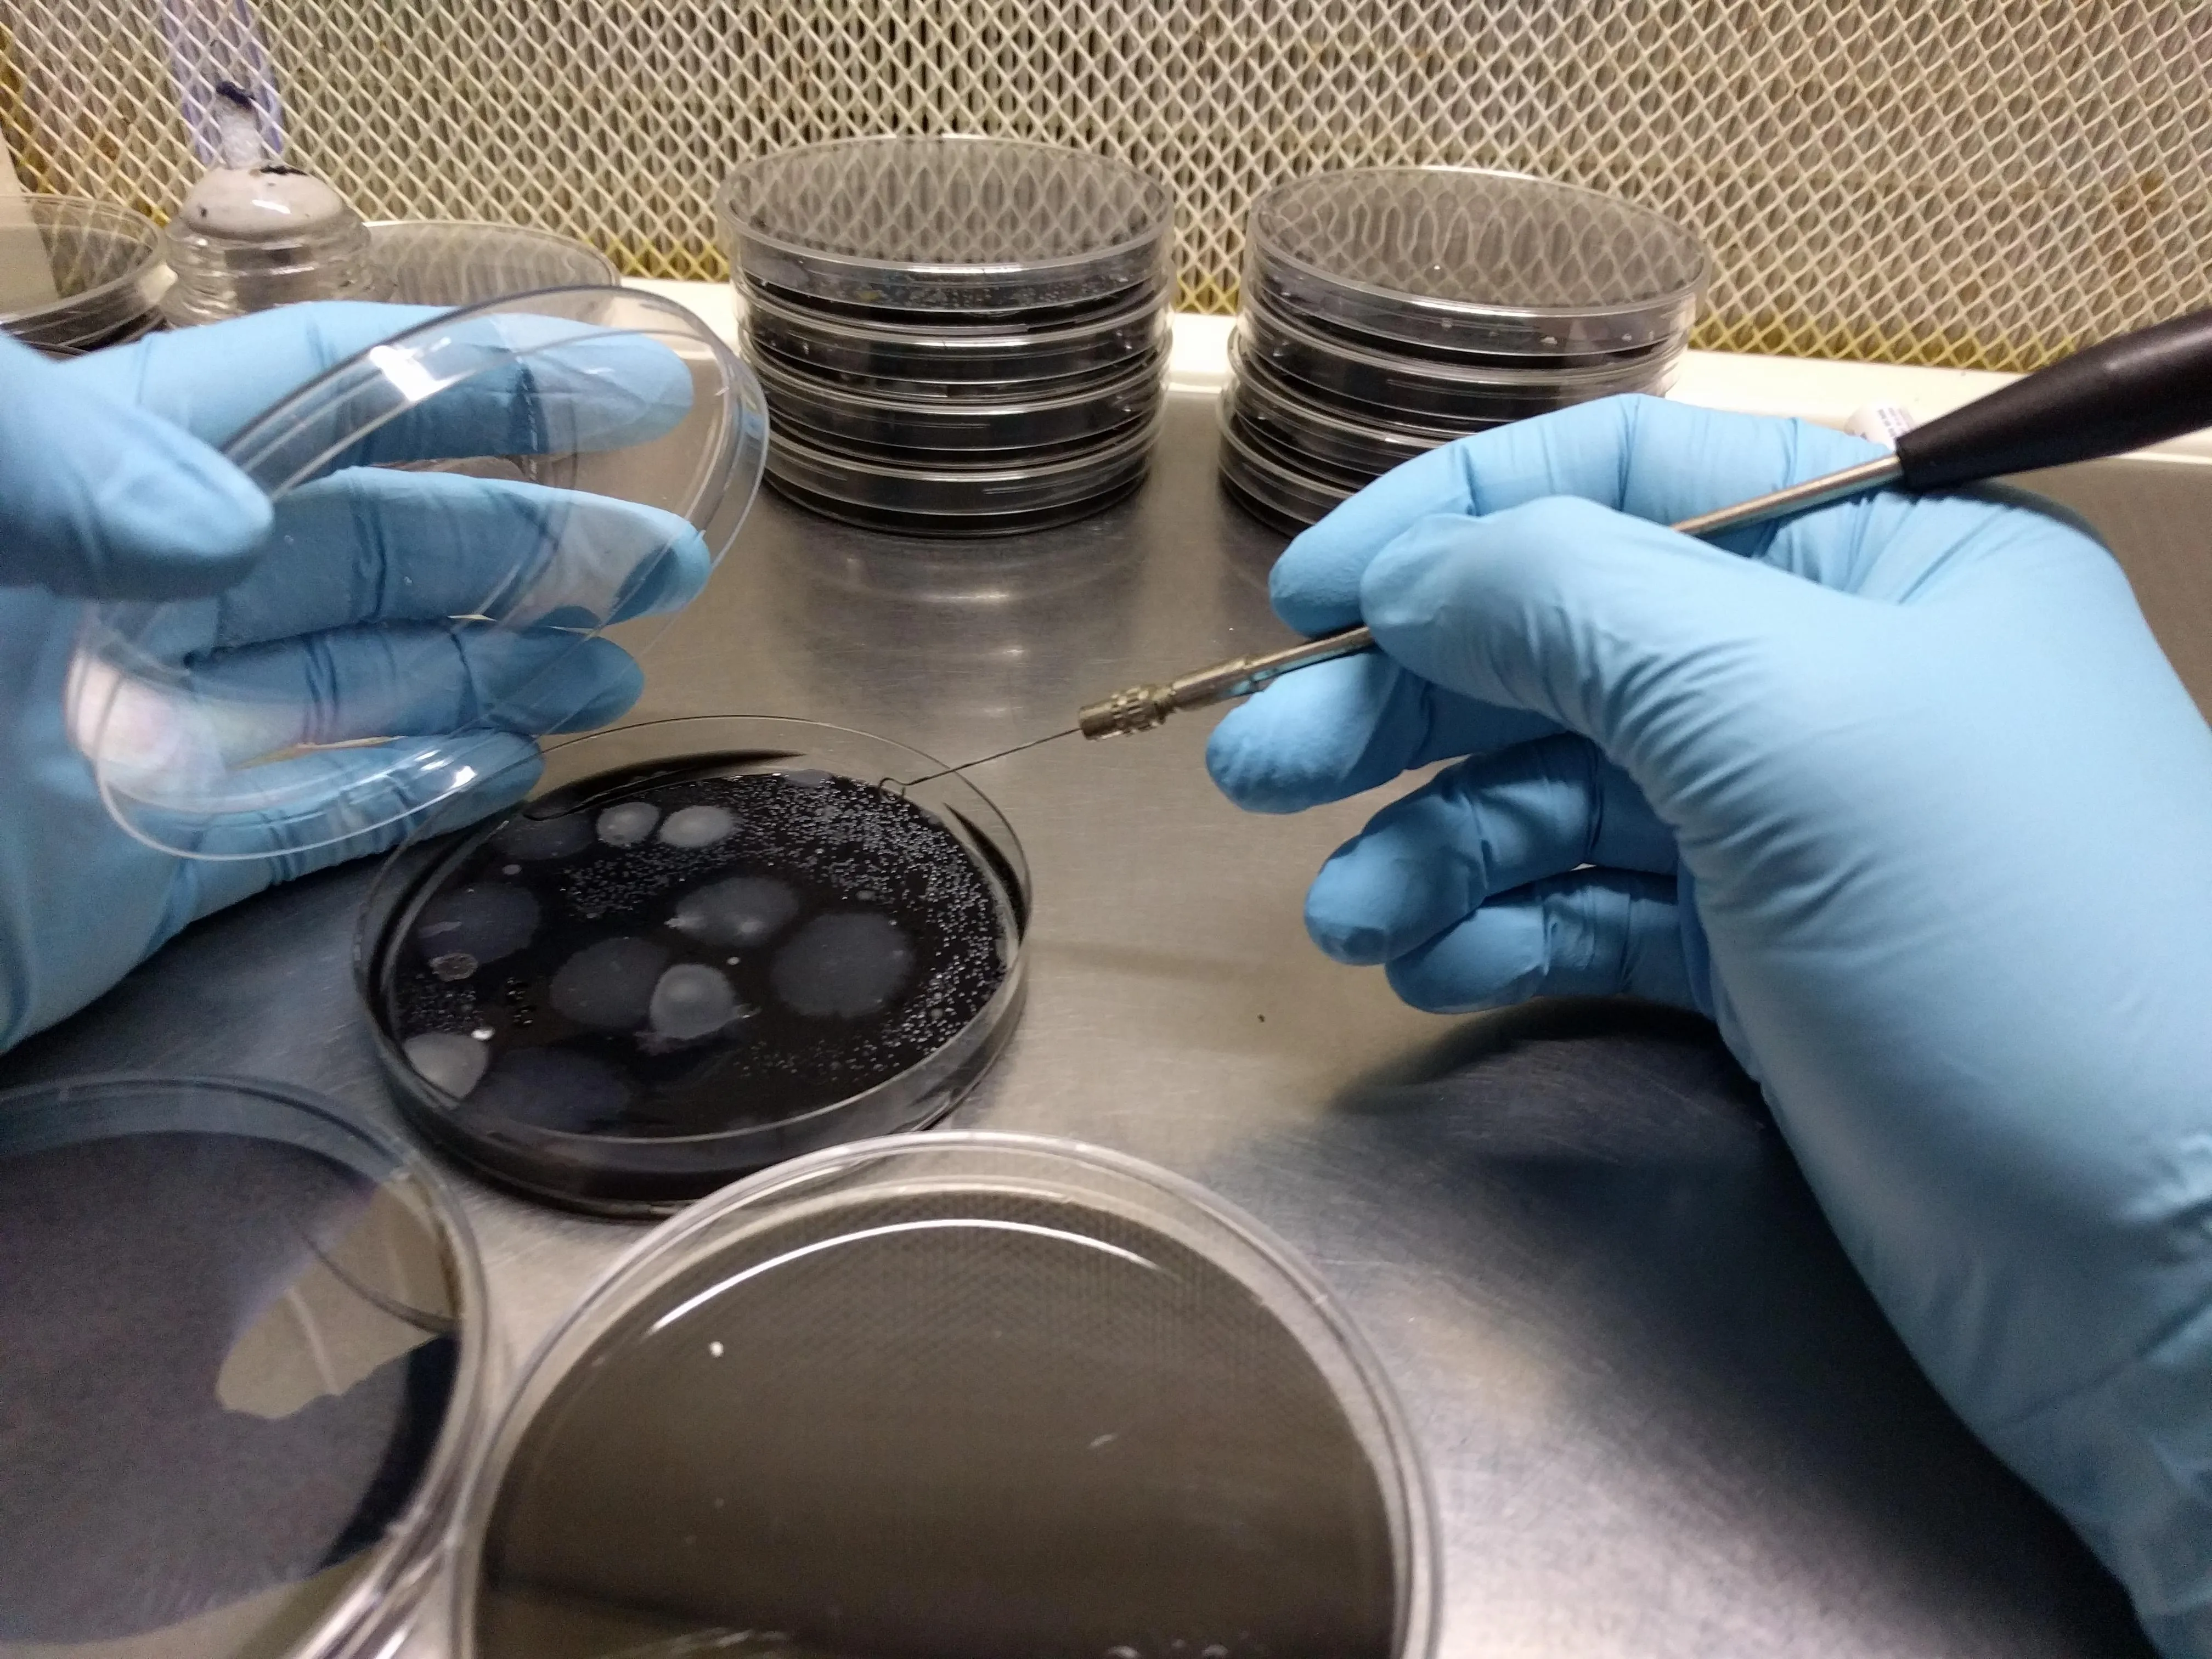

Para ofrecer las mejores experiencias, utilizamos tecnologías como las cookies para almacenar y/o acceder a la información del dispositivo. El consentimiento de estas tecnologías nos permitirá procesar datos como el comportamiento de navegación o las identificaciones únicas en este sitio. No consentir o retirar el consentimiento, puede afectar negativamente a ciertas características y funciones.
El almacenamiento o acceso técnico es estrictamente necesario para el propósito legítimo de permitir el uso de un servicio específico explícitamente solicitado por el abonado o usuario, o con el único propósito de llevar a cabo la transmisión de una comunicación a través de una red de comunicaciones electrónicas.
El almacenamiento o acceso técnico es necesario para la finalidad legítima de almacenar preferencias no solicitadas por el abonado o usuario.
El almacenamiento o acceso técnico que es utilizado exclusivamente con fines estadísticos.
El almacenamiento o acceso técnico que se utiliza exclusivamente con fines estadísticos anónimos. Sin un requerimiento, el cumplimiento voluntario por parte de tu proveedor de servicios de Internet, o los registros adicionales de un tercero, la información almacenada o recuperada sólo para este propósito no se puede utilizar para identificarte.
El almacenamiento o acceso técnico es necesario para crear perfiles de usuario para enviar publicidad, o para rastrear al usuario en una web o en varias web con fines de marketing similares.


 En ARDA2001 realizamos diagnósticos y planes de mejora dirigidos a optimizar la cadena de manipulado y conservación de productos. Proporcionamos recomendaciones técnicas para garantizar un manejo postcosecha eficaz, así como también abordamos la optimización de procesos (cadena de frigoconservación, desinfección y verificación de líneas de confección, tratamientos postcosecha, etc.), reduciendo mermas y mejorando la seguridad alimentaria. Elaboramos informes técnicos para resolver incidencias y apoyarnos en la toma de decisiones: desde la selección de tratamientos y recubrimientos adecuados hasta el seguimiento de cámaras de conservación. En definitiva, ayudamos a cada central a identificar oportunidades de mejora, implementando soluciones prácticas y medibles.
En ARDA2001 realizamos diagnósticos y planes de mejora dirigidos a optimizar la cadena de manipulado y conservación de productos. Proporcionamos recomendaciones técnicas para garantizar un manejo postcosecha eficaz, así como también abordamos la optimización de procesos (cadena de frigoconservación, desinfección y verificación de líneas de confección, tratamientos postcosecha, etc.), reduciendo mermas y mejorando la seguridad alimentaria. Elaboramos informes técnicos para resolver incidencias y apoyarnos en la toma de decisiones: desde la selección de tratamientos y recubrimientos adecuados hasta el seguimiento de cámaras de conservación. En definitiva, ayudamos a cada central a identificar oportunidades de mejora, implementando soluciones prácticas y medibles. Contamos con Laboratorio propio, y para asegurar la validez y fiabilidad de todos los análisis está inscrito en el Registro de Laboratorios Agroalimentarios de Catalunya con el número 433 como reconocido, y en el Registro de Laboratorios de Salut Ambiental y Alimentaria (sección laboratorios autorizados) núm. R1-153-00.
Contamos con Laboratorio propio, y para asegurar la validez y fiabilidad de todos los análisis está inscrito en el Registro de Laboratorios Agroalimentarios de Catalunya con el número 433 como reconocido, y en el Registro de Laboratorios de Salut Ambiental y Alimentaria (sección laboratorios autorizados) núm. R1-153-00. ARDA2001 está habilitada como Empresa Oficial de Ensayos (EOR), autorizada por el Ministerio de Agricultura para realizar ensayos oficiales de registro de productos fitosanitarios. Nuestros ensayos en campo, invernadero y postcosecha siguen los protocolos GEP (Good Experimental Practice) y cumplen con los estándares legales más exigentes para que los resultados puedan ser utilizados por diferentes autoridades de registro (reconocimiento mutuo, evaluación zonal). Esta acreditación oficial valida la rigurosidad de nuestros estudios de eficacia, de modo que los resultados son aceptados como parte del dossier de registro nacional y europeo. De este modo, los fabricantes de fitosanitarios, bioestimulantes y fertilizantes pueden contar con datos fiables y reconocidos legalmente para dar soporte a sus productos.
Realizamos ensayos de eficacia para fitosanitarios, fertilizantes y bioestimulantes:
evaluamos su impacto en el cultivo (rendimiento, calidad, resistencia a estrés) y buscamos demostrar científicamente su beneficio en condiciones reales. Cada proyecto de ensayo incluye diseño experimental, seguimiento técnico continuo (incidencias fitosanitarias, climáticas, etc.) y análisis estadístico de resultados.
∙Ensayos Oficiales (EOR) de productos fitosanitarios, fertilizantes y bioestimulantes.
∙Insecticidas, fungicidas, herbicidas y nematicidas
∙Reguladores de crecimiento
∙Fertilizantes y coadyuvantes
∙Feromonas y trampas
∙Elaboración de informes oficiales para registro de nuevos productos
∙Nuevas tecnologías aplicadas a la agricultura y poscosecha
∙Estudios de campo y laboratorio
∙Ensayos demostrativos para departamentos técnico-comerciales
ARDA2001 está habilitada como Empresa Oficial de Ensayos (EOR), autorizada por el Ministerio de Agricultura para realizar ensayos oficiales de registro de productos fitosanitarios. Nuestros ensayos en campo, invernadero y postcosecha siguen los protocolos GEP (Good Experimental Practice) y cumplen con los estándares legales más exigentes para que los resultados puedan ser utilizados por diferentes autoridades de registro (reconocimiento mutuo, evaluación zonal). Esta acreditación oficial valida la rigurosidad de nuestros estudios de eficacia, de modo que los resultados son aceptados como parte del dossier de registro nacional y europeo. De este modo, los fabricantes de fitosanitarios, bioestimulantes y fertilizantes pueden contar con datos fiables y reconocidos legalmente para dar soporte a sus productos.
Realizamos ensayos de eficacia para fitosanitarios, fertilizantes y bioestimulantes:
evaluamos su impacto en el cultivo (rendimiento, calidad, resistencia a estrés) y buscamos demostrar científicamente su beneficio en condiciones reales. Cada proyecto de ensayo incluye diseño experimental, seguimiento técnico continuo (incidencias fitosanitarias, climáticas, etc.) y análisis estadístico de resultados.
∙Ensayos Oficiales (EOR) de productos fitosanitarios, fertilizantes y bioestimulantes.
∙Insecticidas, fungicidas, herbicidas y nematicidas
∙Reguladores de crecimiento
∙Fertilizantes y coadyuvantes
∙Feromonas y trampas
∙Elaboración de informes oficiales para registro de nuevos productos
∙Nuevas tecnologías aplicadas a la agricultura y poscosecha
∙Estudios de campo y laboratorio
∙Ensayos demostrativos para departamentos técnico-comerciales 